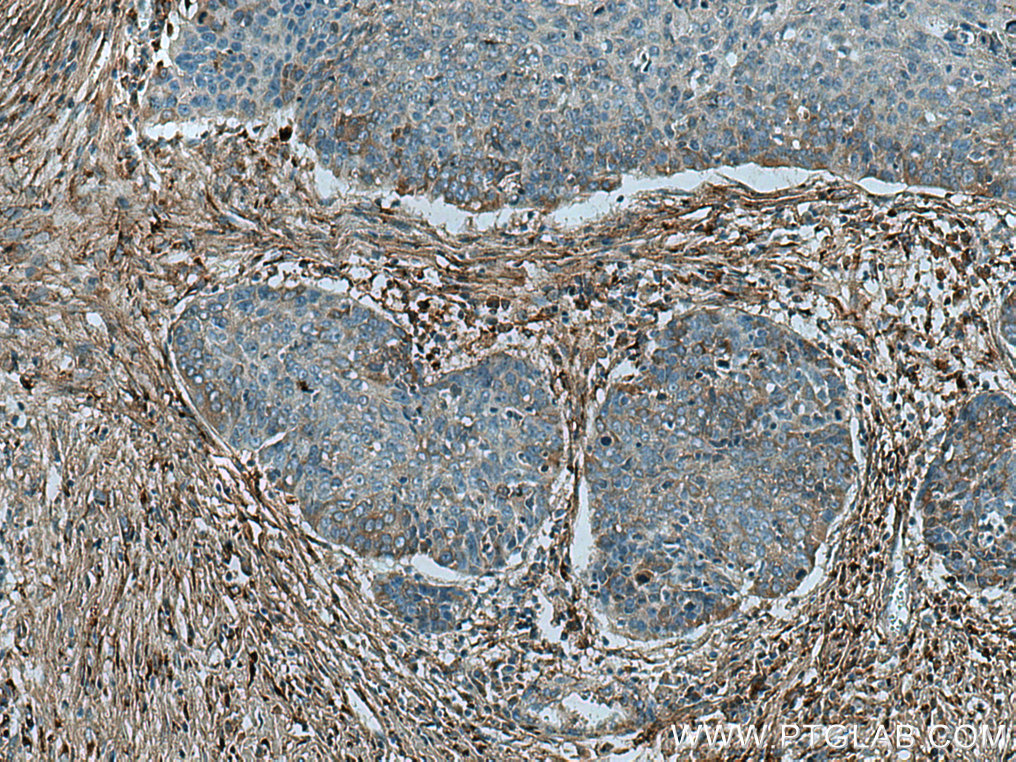
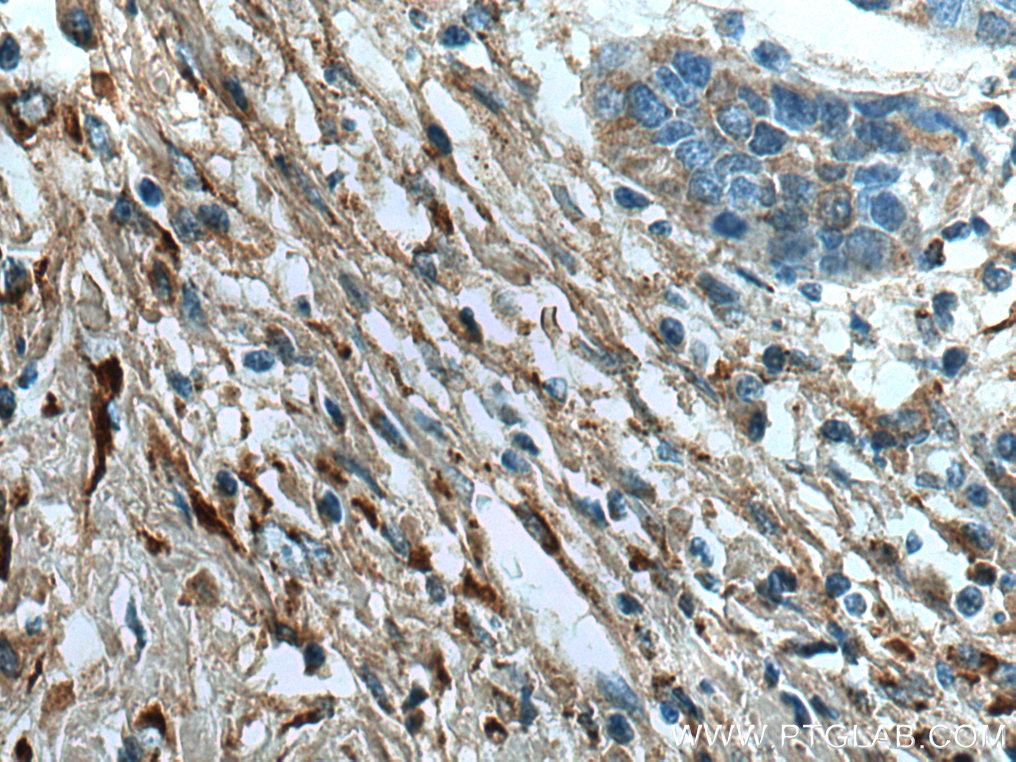

验证数据展示
经过测试的应用
| Positive WB detected in | U-87 MG cells, human placenta tissue, MG-63 cells, pig skin tissue, Saos-2 cells |
| Positive IP detected in | U-87 MG cells |
| Positive IHC detected in | human colon tissue, human breast cancer tissue, human oesophagus cancer tissue, human placenta tissue, human skin cancer tissue, human stomach cancer tissue Note: suggested antigen retrieval with TE buffer pH 9.0; (*) Alternatively, antigen retrieval may be performed with citrate buffer pH 6.0 |
| Positive IF-P detected in | mouse skin tissue |
| Positive FC (Intra) detected in | SW480 cells |
推荐稀释比
| 应用 | 推荐稀释比 |
|---|---|
| Western Blot (WB) | WB : 1:1000-1:6000 |
| Immunoprecipitation (IP) | IP : 0.5-4.0 ug for 1.0-3.0 mg of total protein lysate |
| Immunohistochemistry (IHC) | IHC : 1:500-1:2000 |
| Immunofluorescence (IF)-P | IF-P : 1:200-1:800 |
| Flow Cytometry (FC) (INTRA) | FC (INTRA) : 0.20 ug per 10^6 cells in a 100 µl suspension |
| It is recommended that this reagent should be titrated in each testing system to obtain optimal results. | |
| Sample-dependent, Check data in validation data gallery. | |
产品信息
14695-1-AP targets Collagen Type I in WB, IHC, IF-P, FC (Intra), IP, CoIP, ELISA applications and shows reactivity with human, pig samples.
| 经测试应用 | WB, IHC, IF-P, FC (Intra), IP, ELISA Application Description |
| 文献引用应用 | WB, IHC, IF, FC (Intra), IP, CoIP |
| 经测试反应性 | human, pig |
| 文献引用反应性 | human, mouse, rat, pig, rabbit, canine, chicken, bovine, toad, duck |
| 免疫原 |
CatNo: Ag6281 Product name: Recombinant human COL1A2 protein Source: e coli.-derived, PET28a Tag: 6*His Domain: 1017-1366 aa of BC054498 Sequence: RGLPGLKGHNGLQGLPGIAGHHGDQGAPGSVGPAGPRGPAGPSGPAGKDGRTGHPGTVGPAGIRGPQGHQGPAGPPGPPGPPGPPGVSGGGYDFGYDGDFYRADQPRSAPSLRPKDYEVDATLKSLNNQIETLLTPEGSRKNPARTCRDLRLSHPEWSSGYYWIDPNQGCTMDAIKVYCDFSTGETCIRAQPENIPAKNWYRSSKDKKHVWLGETINAGSQFEYNVEGVTSKEMATQLAFMRLLANYASQNITYHCKNSIAYMDEETGNLKKAVILQGSNDVELVAEGNSRFTYTVLVDGCSKKTNEWGKTIIEYKTNKPSRLPFLDIAPLDIGGADQEFFVDIGPVCFK 种属同源性预测 |
| 宿主/亚型 | Rabbit / IgG |
| 抗体类别 | Polyclonal |
| 产品类型 | Antibody |
| 全称 | collagen, type I, alpha 2 |
| 别名 | COL1, COL1A2, Alpha-2 type I collagen, col I, Collagen alpha 2(I) chain |
| 计算分子量 | 1366 aa, 130 kDa |
| 观测分子量 | 130-160 kDa,210-250kDa |
| GenBank蛋白编号 | BC054498 |
| 基因名称 | COL1A2 |
| Gene ID (NCBI) | 1278 |
| RRID | AB_2082037 |
| 偶联类型 | Unconjugated |
| 形式 | Liquid |
| 纯化方式 | Antigen affinity purification |
| UNIPROT ID | P08123 |
| 储存缓冲液 | PBS with 0.02% sodium azide and 50% glycerol, pH 7.3. |
| 储存条件 | Store at -20°C. Stable for one year after shipment. Aliquoting is unnecessary for -20oC storage. |
背景介绍
Type I collagen, the major structural component of connective tissues such as skin, tendon and bone, is the most abundant and widely expressed collagen in humans (PMID: 7620364; 8645190; 9016532). Type I collagen is a heterotrimer comprising one alpha 2(I) and two alpha 1(I) chains which are encoded by the unlinked loci COL1A2 and COL1A1 respectively. Mutations in COL1A2 gene are associated with osteogenesis imperfecta, Ehlers-Danlos syndrome, idiopathic osteoporosis, and atypical Marfan syndrome. This antibody raised against 1017-1366 aa of human pro-alpha 2 chain of type l collagen can recognize collagen alpha 2(1) chain and C-terminal propeptide of pro-alpha 2(1) chain.
实验方案
| Product Specific Protocols | |
|---|---|
| FC protocol for Collagen Type I antibody 14695-1-AP | Download protocol |
| IF protocol for Collagen Type I antibody 14695-1-AP | Download protocol |
| IHC protocol for Collagen Type I antibody 14695-1-AP | Download protocol |
| IP protocol for Collagen Type I antibody 14695-1-AP | Download protocol |
| WB protocol for Collagen Type I antibody 14695-1-AP | Download protocol |
| Standard Protocols | |
|---|---|
| Click here to view our Standard Protocols |
发表文章
| Species | Application | Title |
|---|---|---|
Adv Mater A Superparamagnetic Composite Hydrogel Scaffold as in Vivo Dynamic Monitorable Theranostic Platform for Osteoarthritis Regeneration | ||
Adv Mater Acid-Induced in Situ Phase Separation and Percolation for Constructing Bi-Continuous Phase Hydrogel Electrodes With Motion-Insensitive Property | ||
Gastroenterology Pancreatic acinar cells-derived sphingosine-1-phosphate contributes to fibrosis of chronic pancreatitis via inducing autophagy and activation of pancreatic stellate cells | ||
Gut Histone methyltransferase Suv39h1 regulates hepatic stellate cell activation and is targetable in liver fibrosis | ||
Bioact Mater 3D Printed Biomimetic Metamaterials with Graded Porosity and Tapering Topology for Improved Cell Seeding and Bone Regeneration |